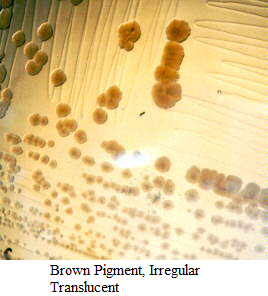
<p>What shape is this?</p>
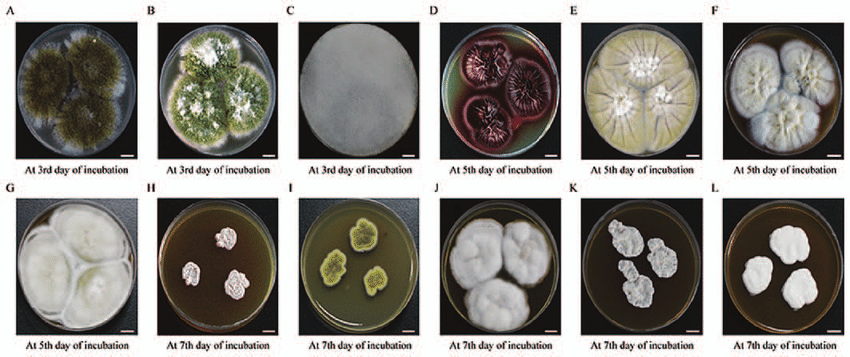
<p>What shape is this?</p>
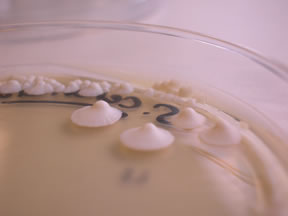
<p>What elevation is this?</p><p></p>

Lab #10: Colony Characteristics and Culture Characteristics
1/31
There's no tags or description
Looks like no tags are added yet.
Name | Mastery | Learn | Test | Matching | Spaced | Call with Kai |
|---|
No analytics yet
Send a link to your students to track their progress
32 Terms
T or F:
The Appearance of Growth is consistent for an organism and is useful to characterize and identify organisms?
True
What are the 7 characteristics of Colony morphology>
Shape
Margin
Elevation
Size
Color
Texture
Optical properties
Where do we view to see the shape for colony morphology?
viewed from above
What is the margin for colony morphology?
outer edge line of colony/ parameter of bacterial colony
What/where is the elevation for colony morphology?
side profile
Describe size as a colony characteristic?
Diameter of colonies in mm
Describe color as a colony characteristic?
the color of the colony
Describe texture as a colony characteristic?
the colony surface
Can be Dull/shiny/glossy/wrinkled/Gooey/crusty/dry/powdery
Describe optical properties as a colony characteristic?
how it transmits light
can be: Opaque, translucent, transparent
What terms are used to characterize colony shape?
round, irregular, filamentous, rhizoid

What shape is this? (the small white circles)
round
What shape is this?
Irregular
-lacks a distinct symmetrical shape
What shape is this?
Filamentous
-hair like, fibrous appearance, resembles a mat

What shape is this?
Rhizoid
-rootlike, branched, spreading out in disticnt segments rather then circular form
What terms are used to characterize colony margin?
Smooth, irregular, filamentous, rhizoid, lobate
What terms are used to characterize the elevation?
flat, raised, convex, umbonate, plateau, raised margin
What elevation is this?
Umbonate

What elevation is this? Name in order
raised, flat, convex, umbonate, growth into medium
What elevation is this?
slightly raised but flat
plateau
what optical property is this?
-completely blocks light from passing through, appears solid, colored or white
Opaque
what optical property is this?
-partially transparent, allowing light to pass through but scattering it enough to prevent clear imaging, often resembling frosted glass
Transluscent
what optical property is this?
-Clear, allows light to pass through
Transparent

What culture characteristics in broth is this?
Pellicle

What culture characteristics in broth is this?
ring

What culture characteristics in broth is this?
sediment

What culture characteristics in broth is this?
flocculent

What culture characteristics in broth is this?
turbid

Identify this bacterial growth in an agar plate
-growth resembles a string of beads along the lines of inoculation
Beaded
Identify this bacterial growth in an agar plate
-growth appears toothlike
echinulate
Identify this bacterial growth in an agar plate
-uniform growth along the line of inoculation
Filiform
Identify this bacterial growth in an agar plate
-branched and rootlike appearance
rhizoid
Identify this bacterial growth in an agar plate
-growth spreading away from line of inoculation
Spreading